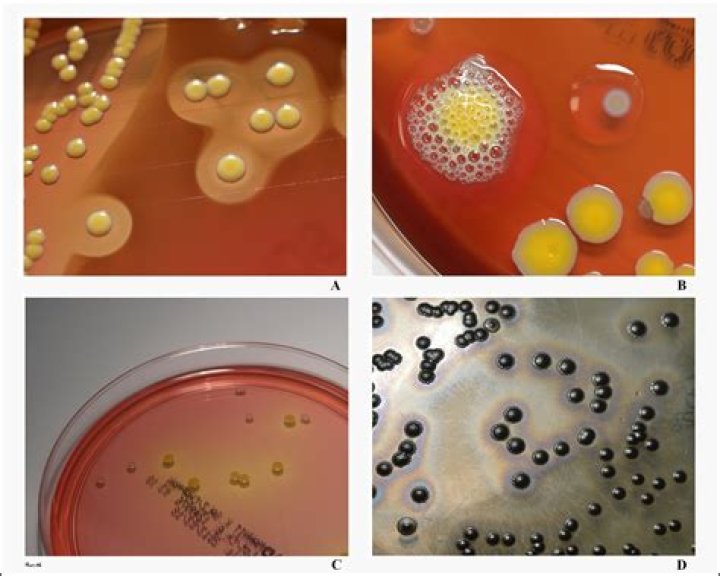

Is staphylococcus catalase positive?
Staphylococcus aureus is a gram positive, catalase and coagulase positive coccus and by far the most important pathogen among the staphylococci. It produces enzymes such as catalase which are considered to be virulence determinants.
Why is Staphylococcus catalase positive?
Catalase is an enzyme that converts hydrogen peroxide to water and oxygen gas. The test is easy to perform; bacteria are simply mixed with H 2O 2. If bubbles appear (due to the production of oxygen gas) the bacteria are catalase positive.
Is Staphylococcus catalase negative?
Staphylococcus species are catalase positive and facultatively anaerobic, except for S. aureus subsp. anaerobius and S. saccharolyticus, which are catalase negative and anaerobic.
Are Streptococcus catalase positive?
Gram-positive cocci include Staphylococcus (catalase-positive), which grows clusters, and Streptococcus (catalase-negative), which grows in chains.
Is Staphylococcus pyogenes catalase positive?
S. pyogenes is a gram-positive, β-hemolytic streptococcus that is catalase negative.
Staphylococcus aureus Biochemical Tests | Catalase Test | Coagulase Test | Basic Science Series
35 related questions foundIs Staph aureus catalase positive or negative?
Staphylococcus aureus is a gram positive, catalase and coagulase positive coccus and by far the most important pathogen among the staphylococci. It produces enzymes such as catalase which are considered to be virulence determinants.
Which organisms are catalase positive?
Staphylococci and Micrococci are catalase-positive. Other catalase-positive organisms include Listeria, Corynebacterium diphtheriae, Burkholderia cepacia, Nocardia, the family Enterobacteriaceae (Citrobacter, E.
What bacteria is positive for catalase test?
If no bubbles appear, the bacteria are catalase negative. Staphylococcus and Micrococcus spp. are catalase positive, whereas Streptococcus and Enterococcus spp. are catalase negative.
Is Staph aureus Gram-positive?
Staphylococcus aureus is a gram-positive bacteria that cause a wide variety of clinical diseases. Infections caused by this pathogen are common both in community-acquired and hospital-acquired settings.
What is the difference between Staphylococcus and Staphylococcus aureus?
Staphylococci are Gram-positive cocci that grow in clumps, are catalase test positive and coagulase test positive (Staph. aureus) or negative (coagulase-negative staphylococci). Staph. aureus is the most important pathogen, causing a variety of pyogenic infections and toxin-mediated illnesses in normal hosts.
Is Staphylococcus aureus mannitol positive?
Most non-pathogenic staphylococci will not ferment mannitol. The Staphylococcus aureus ferments mannitol and turns the medium yellow. The Serratia marcescens does not grow because of the high salt content.
Is catalase present in Staphylococcus epidermidis?
epidermidis being a catalase-producing bacterium29, the role of catalase in the tolerance of S.
Is Escherichia coli catalase positive?
Escherichia coli and Streptococcus pneumoniae have been used as model catalase-positive and catalase-negative bacteria, respectively.
Is Staphylococcus epidermidis Gram positive or negative?
Staphylococcus epidermidis which is known as a coagulase-negative and Gram-positive Staphylococcus, is one of the five significant microorganisms that are located on human skin and mucosal surfaces with the ability of causing nosocomial infections due to the wide usage of medical implants and devices, hence until 1980 ...
Are all aerobic bacteria catalase positive?
Organisms that are catalase positive might be obligate aerobes (all have catalase) or facultative anaerobes (many have catalase). Organisms that are negative for the catalase test (no bubbling) lack the enzyme catalase.
Why is Staphylococcus aureus Gram-positive?
Gram-positive bacteria such as Staphylococcus aureus have cell walls that lack an outer membrane. Instead, they have a single cytoplasmic membrane surrounded by a thick exposed peptidoglycan layer.
What is Gram-positive staph infection?
Staphylococci are gram-positive aerobic organisms. Staphylococcus aureus is the most pathogenic; it typically causes skin infections and sometimes pneumonia, endocarditis, and osteomyelitis. It commonly leads to abscess formation.
What is Gram-positive and Gram negative organisms?
Bacteria with thick peptidoglycan are called gram positive. If the peptidoglycan layer is thin, it's classified as gram negative.
What does a positive catalase test show?
The catalase test tests for the presence of catalase, an enzyme that breaks down the harmful substance hydrogen peroxide into water and oxygen. ... Bubbles are a positive result for the presence of catalase. If no bubbles form, it is a negative result; this suggests that the organism does not produce catalase.
Is Klebsiella catalase positive?
Klebsiella species are cytochrome oxidase negative and catalase positive. Other typical Enterobacteriaceae taxonomical tests vary among the species: indole, methyl red, Voges–Proskauer and Simmons citrate. They are usually lysine decarboxylase positive and ornithine decarboxylase negative.
What two groups of bacteria that can be differentiated with the catalase test?
The catalase test is used to differentiate staphylococci (catalase-positive) from streptococci (catalase-negative). The enzyme, catalase, is produced by bacteria that respire using oxygen, and protects them from the toxic by-products of oxygen metabolism.
Is Streptococcus pyogenes catalase positive or negative?
Moreover, it causes invasive infections like necrotizing fasciitis and toxic shock syndrome that is associated with and high morbidity and mortality. Streptococci are gram-positive, catalase-negative, coagulase-negative cocci that occur in pairs or chains.
Is Pseudomonas aeruginosa catalase positive?
Biochemical characterization of these isolates revealed that 21 samples were typical in nature, i.e., positive for oxidase, catalase, citrate utilization, nitrate reduction, and glucose fermentation whereas were negative for methyl red, Voges-Proskauer, and indole tests. Two [2] Pseudomonas sp.
Is Citrobacter catalase positive?
Members of the genus Citrobacter share all the general properties and biochemical characteristics of the family Enterobacteriaceae, including the following: gram-negative rod, catalase-positive and oxidase-negative, growth on MacConkey agar, reduction of nitrate to nitrite, growth both aerobically and anaerobically, ...
Which Agar is used for catalase test?
Place a small amount of growth from your culture on to a clean microscope slide. If using colonies from a blood agar plate, be very careful not to scrape up any of the blood agar—blood cells are catalase positive and any contaminating agar could give a false positive. 2. Add a drop of Catalase Reagent onto the smear.



